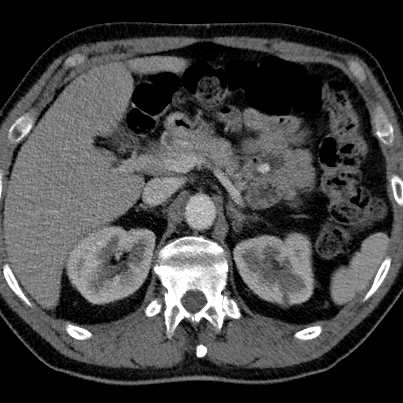

Jejunal hyperdensity
Routine CT shows focal increased density in jejunum, in patient who presented with LUQ pain, diffrential includes enhancing mass and acute bleed.
Virtual non-contrast shows corresponding hyperdensity, consistent with ingested medication. No further work-up needed.